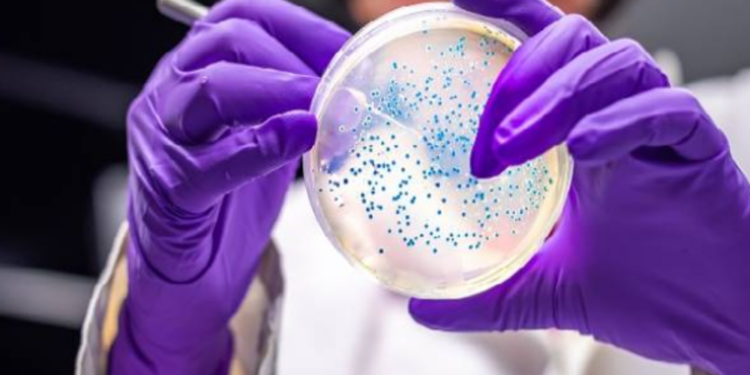
நாட்டிலுள்ள பெண்கள் தொடர்பில் எச்சரிக்கை!

லெப்டோஸ்பிரோசிஸ் எனும் எலிகாய்ச்சல் நோயால் அதிகளவான பெண்கள் பாதிக்கப்பட்டு வருவதை கண்டறிந்துள்ளதாக இலங்கையின் சுகாதார அதிகாரிகள் மருத்துவ கலாநிதி துசானி டபரேரா எச்சரிக்கை விடுத்துள்ளார்.
நெற் பயிர்செய்கை, கால்நடை வளர்ப்பு மற்றும் சுரங்கம் தோண்டுதல் போன்ற அதிக ஆபத்துள்ள தொழில்களில் ஈடுபடும் ஆண்கள் மத்தியிலேயே இந்த நோயின் தாக்கம் முன்பு இருந்து வந்தது.
எனினும் பல ஆண்டுகளாக, பெண்கள் லெப்டோஸ்பிரோசிஸ் நோயால் பாதிக்கப்படும் நிலை உருவாகி வருகிறது.
அந்தவகையில் கடந்த ஆண்டு கிட்டத்தட்ட 9,000 நோய்த்தொற்றாளர்கள் இனங்காணப்பட்டுள்ளதுடன் இந்த ஆண்டில் இதுவரை 5,000 தொற்றுக்கள் பதிவாகியுள்ளன.
இந்த தொற்றுக்களில் பெரும்பாலானவை இரத்தினபுரி, கேகாலை, காலி, களுத்துறை, மொனராகலை மற்றும் குருநாகல் போன்ற பிரதேசங்களில் கண்டறியப்பட்டுள்ளன.
இந்நிலையில், கடுமையான மழையைத் தொடர்ந்து தொற்றுநோய்களின் அபாயம் அதிகரிக்கிறது இந்த நோய் தசை வலி, மஞ்சள் காமாலை, இருமல், மூச்சுத் திணறல் போன்ற அறிகுறிகளுடன் வெளிப்படுகிறது.
இறுதியாக, கடுமையான சந்தர்ப்பங்களில் சிறுநீரகம், இதயம் அல்லது சுவாச செயலிழப்புக்கு இந்த நோய் வழிவகுக்கும் என்றும் தொற்றுநோயியல் பிரிவின் ஆலோசகர் மருத்துவ கலாநிதி துசானி டபரேரா தெரிவித்துள்ளார்.